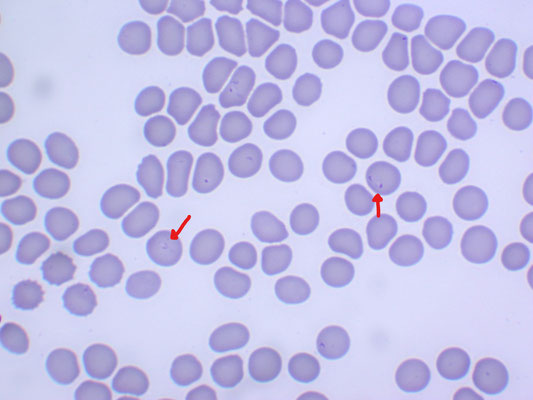

バベシア症
掲載情報について
各種情報は、あなぶきヘルスケア株式会社が調査した情報を基に掲載しています。
正確な情報掲載を務めておりますが、内容を完全に保証するものではありません。
掲載されている施設への受診や訪問及び求職する場合は、事前に必ず該当の施設に直接ご確認ください。
当サービスによって生じた損害について、あなぶきヘルスケア株式会社ではその賠償の責任を一切負わないものとします。
情報に誤りがある場合には、お手数をおかけいたしますが、あなぶきヘルスケア株式会社までご連絡をお願いいたします。